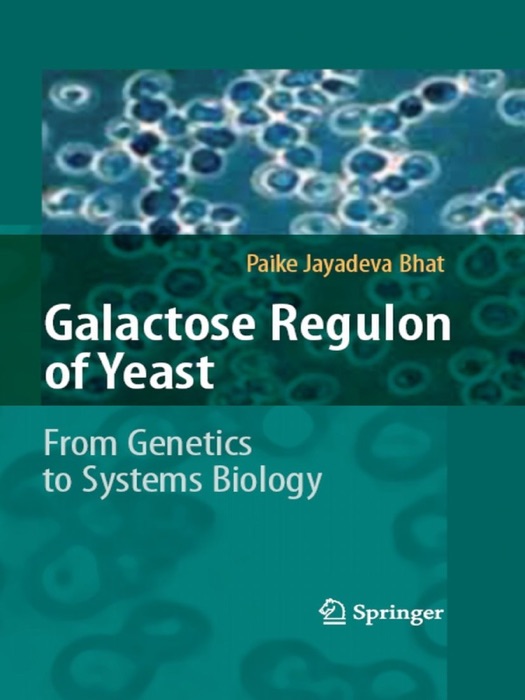

[Download] "Galactose Regulon of Yeast" by Paike Jayadeva Bhat # eBook PDF Kindle ePub Free
eBook details
- Title: Galactose Regulon of Yeast
- Author : Paike Jayadeva Bhat
- Release Date : January 02, 2008
- Genre: Life Sciences,Books,Science & Nature,
- Pages : * pages
- Size : 3253 KB
Description
The galactose regulon of yeast is one of the best studied regulons. It is an ideal paradigm for demonstrating fundamental and evolving concepts in biology and is used in this book as a model system to explain various facets of conventional and modern biology.
The book starts with a brief historical overview on yeast research, i.e. early observations in enzyme adaptation, classical genetics, formulating hypotheses based on genetic inference. This is followed by molecular genetics of the galactose regulon, isolation of genes and testing of the hypotheses. The power of mutational analysis in deciphering molecular mechanisms is conveyed. Further, contemporary topics such as genomics, evolution, single cell analysis of transcriptional switching, binary and graded responses, biological consequences of feed back regulation in genetic circuits, and stochasticity are addressed.